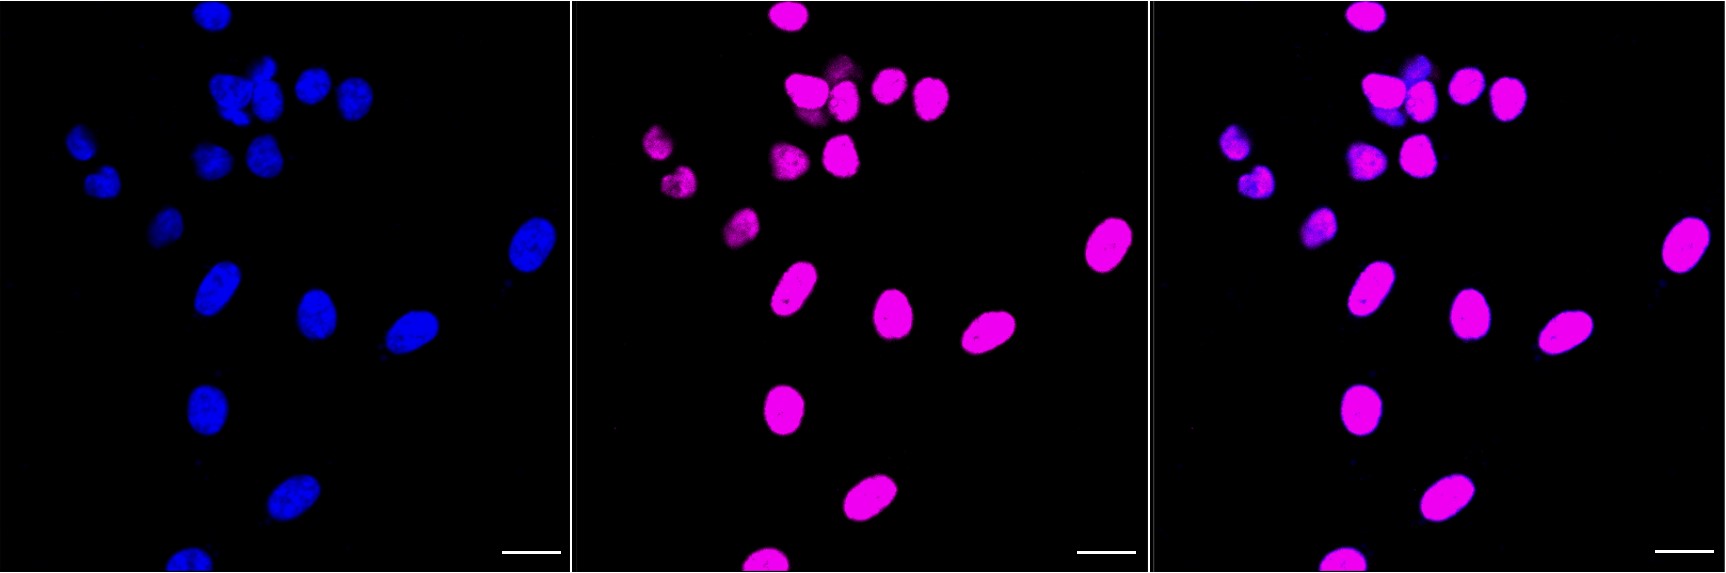

HDAC9 Recombinant Monoclonal Antibody
-
中文名稱:HDAC9 Recombinant Monoclonal Antibody
-
貨號:CSB-RA794686A0HU
-
規格:¥1320
-
圖片:
-
Flow cytometric analysis of histone deacetylase 9 expression in HepG2 cells using histone deacetylase 9 antibody. Green, isotype control; red, histone deacetylase 9.
-
Immunocytochemical staining of HepG2 cells with Histone deacetylase 9 antibody. Nuclei were stained blue with DAPI; Histone deacetylase 9 was stained magenta with Alexa Fluor? 647. Images were taken using Leica stellaris 5. Protein abundance based on laser Intensity and smart gain: Medium. Scale bar, 20 μm.
-
Western blotting analysis using histone deacetylase 9 antibody. Total cell lysates (30 μg) from various cell lines were loaded and separated by SDS-PAGE. The blot was incubated with histone deacetylase 9 antibody and HRP-conjugated goat anti-rabbit secondary antibody respectively.
-
-
其他:
產品詳情
-
Uniprot No.:
-
基因名:HDAC9
-
別名:HDAC9; Histone Deacetylase 9; HDAC7B; MITR; HD7; KIAA0744; HDAC; Histone Deacetylase 7B; EC 3.5.1.98; HDAC; HD7b; HDRP; HD9; MEF-2 Interacting Transcription Repressor (MITR) Protein; MEF2-Interacting Transcription Repressor MITR; Histone Deacetylase 4/5-Related Protein; Histone Deacetylase-Related Protein; HDAC9FL; ARCND4; HDAC9B
-
反應種屬:Human
-
免疫原:Recombinant Human HDAC9 protein
-
免疫原種屬:Homo sapiens (Human)
-
標記方式:Non-conjugated
-
克隆類型:Monoclonal
-
抗體亞型:Rabbit IgG
-
純化方式:Affinity-chromatography
-
克隆號:11H4
-
濃度:It differs from different batches. Please contact us to confirm it.
-
保存緩沖液:Rabbit IgG in PBS (pH 7.4) containing 50% glycerol, and 0.02% sodium azide.
-
產品提供形式:Liquid
-
應用范圍:ELISA, WB, FC, ICC
-
推薦稀釋比:
Application Recommended Dilution WB 1:4000-1:20000 FC 1:200-1:2000 ICC 1:100-1:1000 -
Protocols:
-
儲存條件:Upon receipt, store at -20°C or -80°C. Avoid repeated freeze.
-
貨期:Basically, we can dispatch the products out in 1-3 working days after receiving your orders. Delivery time maybe differs from different purchasing way or location, please kindly consult your local distributors for specific delivery time.
-
用途:For Research Use Only. Not for use in diagnostic or therapeutic procedures.
相關產品
靶點詳情
-
功能:Responsible for the deacetylation of lysine residues on the N-terminal part of the core histones (H2A, H2B, H3 and H4). Histone deacetylation gives a tag for epigenetic repression and plays an important role in transcriptional regulation, cell cycle progression and developmental events. Represses MEF2-dependent transcription.; Isoform 3 lacks active site residues and therefore is catalytically inactive. Represses MEF2-dependent transcription by recruiting HDAC1 and/or HDAC3. Seems to inhibit skeletal myogenesis and to be involved in heart development. Protects neurons from apoptosis, both by inhibiting JUN phosphorylation by MAPK10 and by repressing JUN transcription via HDAC1 recruitment to JUN promoter.
-
基因功能參考文獻:
- This study highlights HDAC9 as a mediator of cell invasion and angiogenesis in Triple negative breast cancer (TNBC) cells through VEGF and MAPK3 by modulating miR-206 expression and suggests that selective inhibition of HDAC9 may be an efficient route for TNBC therapy. PMID: 29936177
- the T allele of rs2107595 in HDAC9 increases the risk of stroke but that the G allele of rs2389995 decreases the risk of stroke in the Chinese population (Meta-Analysis) PMID: 28145521
- HDAC9 may be a new indicator for assessing chronic heart failure. PMID: 30074176
- HDAC9 may be involved in the process of diabetic nephropathy. PMID: 27633396
- HDAC9, in cooperation with BRG1 and MALAT1, mediates a critical epigenetic pathway responsible for vascular smooth muscle cells dysfunction. PMID: 29520069
- M4 macrophages are a possible source for HDAC9 and MMP12 expression in advanced human carotid plaques. PMID: 28343758
- HDAC9 is an important epigenetic factor regulating ox-LDL-induced endothelial cell apoptosis and inflammatory factor expression. PMID: 27100479
- decline in HDAC9c expression over time was accompanied by increased EZH2 expression. PMID: 27250566
- HDAC9 might contribute to lymphomagenesis by altering pathways involved in growth and survival, as well as modulating BCL6 activity and p53 tumor suppressor function. PMID: 27799148
- post-translational modification of Nkx3.2 employing HDAC9-PIASy-RNF4 axis plays a crucial role in controlling chondrocyte viability and hypertrophic maturation during skeletal development in vertebrates. PMID: 27312341
- Data show that the gene encoding the transcription factor SOX9 was identified by a global transcriptomic approach as an HDAC9 target gene. PMID: 26930713
- The minor allele A of SNP rs2107595 increased coronary artery disease risk and the severity of coronary atherosclerosis in a Chinese Han population. PMID: 27494404
- in leiomyosarcomas (LMS), this two-faced trait of MEF2 is relevant for tumor aggressiveness. Class IIa HDACs are overexpressed in 22% of LMS, where high levels of MEF2, HDAC4 and HDAC9 inversely correlate with overall survival. The knock out of HDAC9 suppresses the transformed phenotype of LMS cells, by restoring the transcriptional proficiency of some MEF2-target loci PMID: 28419090
- Based on this study, it is suggested that HDAC9 regulates the formation of APBs and could be a candidate for the target of ALT-cancer therapy. PMID: 27833022
- PC3/Tis21 associates with HDAC1, HDAC4, and HDAC9 in vivo, in fibroblast cells. PMID: 27333946
- HDAC9 is a target of miR-377 in oral squamous cell carcinoma. PMID: 28267394
- Studied HDAC9 gene's association with an increased susceptibility to acute coronary syndrome (ACS) in Chinese Han population. The results revealed a significant association of rs2240419 with ACS risk in which the A allele (P = 0.047) and the A allele carriers (AA + AG) (P = 0.037) were more likely to be in ACS group as compared to those in the control group. PMID: 27642596
- Downregulation of HDAC9 promotes gliomas. PMID: 27495233
- overexpression of HDAC9 contributes to OSCC carcinogenesis via targeting a transcription factor, MEF2D, and NR4A1/Nur77, a pro-apoptotic MEF2 target PMID: 26992905
- The aurora kinase A inhibited by MLN 8054 are both implicated in cell cycle progression and, thus, in cellular proliferation.Epigenetic regulators were targeted by SAHA inhibiting HDACs and by DZNep inhibiting the histone methyltransferase EZH2, which silences genes by trimethylating histone H3K27.Combinations of small molecular inhibitors act synergistically in rhabdoid tumor PMID: 27466490
- These results highlighting the significant correlation between TWIST and HDAC9 gene expression suggest that both genes may contribute to plaque stability in a coordinated way PMID: 26621503
- Polymorphisms of HDAC9 is associated with Ischemic Stroke. PMID: 26347468
- The results imply that HDAC9 is involved in the transcriptional regulation of human odontoblasts in vivo. PMID: 22297573
- HDAC9 was commonly expressed in retinoblastoma tissues and HDAC9 was overexpressed in prognostically poor retinoblastoma patients. PMID: 27033599
- HDAC9 promotes tumor formation of glioblastoma via TAZ-mediated EGFR pathway activation. PMID: 25760078
- the results of this study suggest that targeting HDACs by ST-3595 might represent as a novel and promising anti-pancreatic cancer strategy. PMID: 26084607
- results indicate that HDAC9 variant rs2107595 may be not associated with IS risk in southern Han Chinese PMID: 26093197
- Data show that miR-376a and HDAC9 expression are inversely correlated in hepatocellular carcinoma and suggest that HDAC9-mediated epigenetic modification may contribute to the down-regulation of the miR-376 cluster in hepatocellular carcinoma. PMID: 25613642
- Gene expression studies in peripheral blood mononuclear cells revealed increased mRNA levels of HDAC9. Analysis of human atherosclerotic plaques revealed no association between rs2107595 and specific plaque characteristics. PMID: 25388417
- The hydroxamic acid pan-HDAC inhibitor TSA synergistically inhibit the viability. PMID: 24562770
- The results elucidate the genetic etiology of lung adenocarcinoma by demonstrating that SNP rs10248565 in the HDAC9 gene may be a potential biomarker of cancer susceptibility. PMID: 24650256
- These results suggest that HDAC9 may be a suppressor and its downregulation might promote the progression process, especially in lung adenocarcinomas. PMID: 24427341
- study reports gene expression in skeletal muscle tissue of women with metabolic syndrome is enriched in inflammatory response-related genes; IL6R, HDAC9 and CD97 expression correlated negatively with insulin sensitivity; suggests a role for these 3 inflammatory genes in development of skeletal muscle insulin resistance in women PMID: 23771909
- These data suggest that HDAC9 variants may be selected for during cutaneous squamous cell carcinoma tumorigenesis PMID: 23784969
- In vivo sorafenib + HDAC inhibitor toxicity against tumors was increased. PMID: 23674352
- HDAC9 gene is significantly associated with large-vessel stroke risk in Chinese population. PMID: 23828597
- We propose that CtBP2 is an ovarian cancer oncogene that regulates gene expression program by modulating HDAC activity. PMID: 22945647
- SNP, rs12155400, in the histone deacetylase 9 gene (HDAC9) on chromosome 7, was associated with retinopathy in analysis of participants without hypertension PMID: 23393555
- Our results are consistent with the 7p21.1 association acting via promoting atherosclerosis, and consistent with alterations in HDAC9 expression mediating this increased risk. PMID: 23449258
- Regression models consistently identified rs2522129, rs2675231, and rs2389963 as having among the highest predictive values for explaining differences related to brain volume measures PMID: 22884548
- Dephosphorylation at a conserved SP motif governs cAMP sensitivity and nuclear localization of class IIa histone deacetylases HDAC4, 5 and 9 PMID: 23297420
- HDAC9 promotes angiogenesis and transcriptionally represses the endothelial cell miR-17-92 cluster. PMID: 23288173
- LBH589 and TSA may translationally regulate some HDAC encoding genes in pancreatic tumors. PMID: 22487525
- Data indicate a pronounced deregulation of HDAC genes HDAC9 and HDAC11 in patients with Philadelphia-negative chronic myeloproliferative neoplasms: essential thrombocythemia (ET), polycythemia vera (PV) and primary myelofibrosis (PMF). PMID: 21806350
- We identified a new association for large vessel stroke within HDAC9 on chromosome 7p21.1. PMID: 22306652
- Treated the seminoma-like cell line TCam-2 with the HDAC-inhibitor Depsipeptide. PMID: 21987446
- The results show that hdac9 is the third androgenic alopecia susceptibility gene PMID: 22032556
- HDAC9 acts as an epigenetic switch in effector T cell-mediated systemic autoimmunity. PMID: 21708950
- HDAC suppresses the activation of PPARgamma in the gastric carcinoma cell line SGC-7901. PMID: 19624894
- MITR plays a master switch role to balance osteogenic and adipogenic differentiation of MSCs through regulation of PPARgamma-2 transcriptional activity. PMID: 21247904
顯示更多
收起更多
-
相關疾病:A chromosomal aberration involving HDAC9 is found in a family with Peters anomaly. Translocation t(1;7)(q41;p21) with TGFB2 resulting in lack of HDAC9 protein.
-
亞細胞定位:Nucleus.
-
蛋白家族:Histone deacetylase family, HD type 2 subfamily
-
組織特異性:Broadly expressed, with highest levels in brain, heart, muscle and testis. Isoform 3 is present in human bladder carcinoma cells (at protein level).
-
數據庫鏈接:
Most popular with customers
-
-
YWHAB Recombinant Monoclonal Antibody
Applications: ELISA, WB, IHC, IF, FC
Species Reactivity: Human, Mouse, Rat
-
Phospho-YAP1 (S127) Recombinant Monoclonal Antibody
Applications: ELISA, WB, IHC
Species Reactivity: Human
-
-
-
-
-